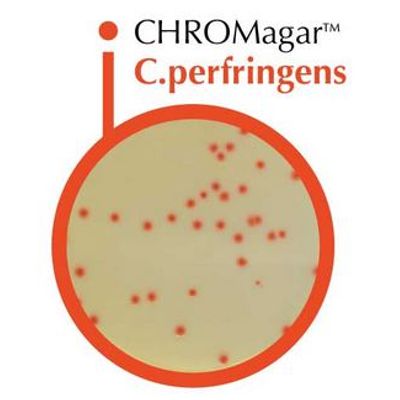

Scharlab,S.L.
- Home
- Companies
- Scharlab,S.L.
- Products
- CHROMagar - Model C - Perfringens

CHROMagar - Model C -Perfringens
FromScharlab,S.L.
Chromogenic dehydrated medium for detection and enumeration of Clostridium perfringens.

Chromogenic dehydrated medium for detection and enumeration of Clostridium perfringens.